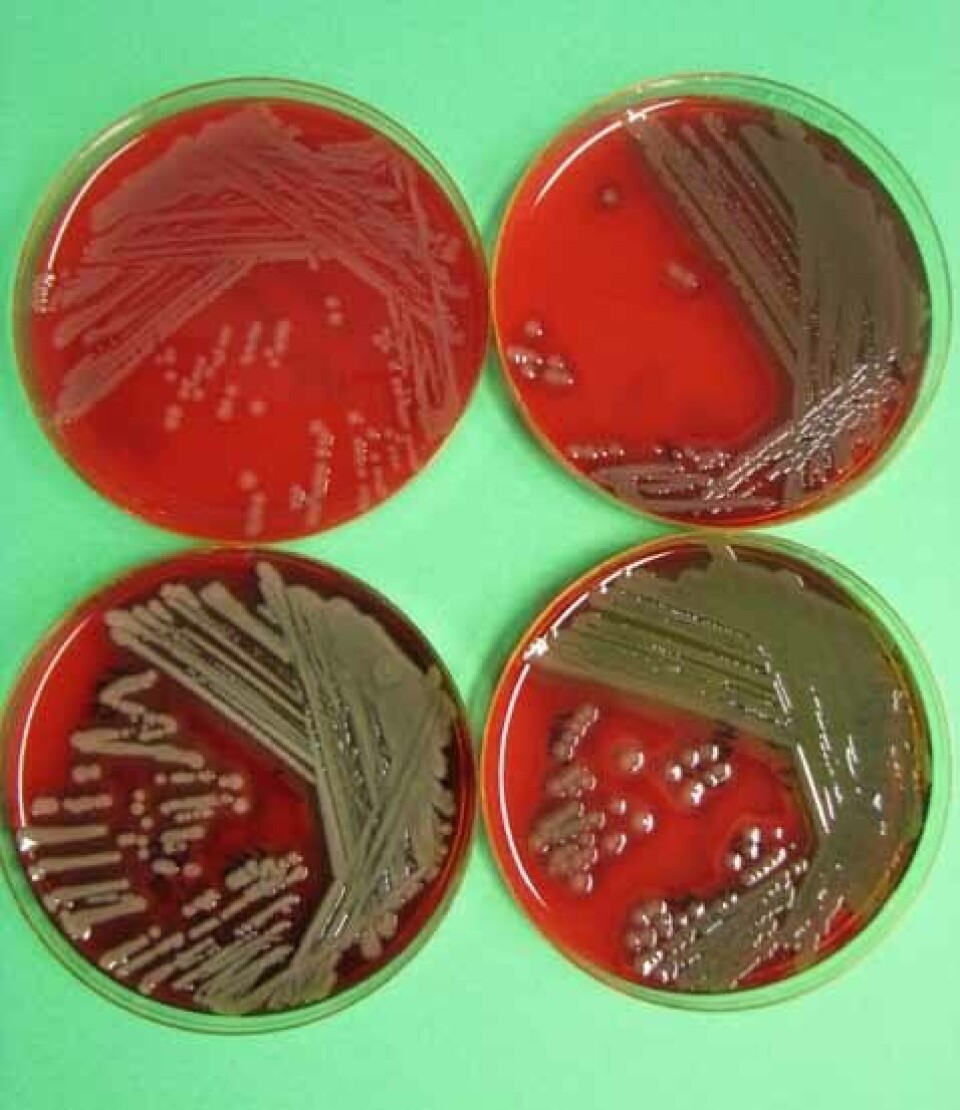
Vibrio spp isolert  fra leppfisk.  Foto Hanne Nilsen.

Laveste antibiotikabruk siden 70-tallet
Bruken av antibiotika til fisk var rekordlavt i fjor. Men det var mange forskrivninger – men ikke til laks.
Denne artikkelen er tre år eller eldre.
I Fiskehelserapporten for 2016 kommenterer Atle Lillehaug, Edgar Brun og Brit Hjeltnes, alle fra Veterinærinstituttet utviklingen innen fiskehelse.
De påpeker at forbruket av antibakterielle midler er en god indikator på forekomsten av bakterielle sykdommer.
- Helt siden vaksiner mot kaldtvannsvibriose og furunkulose ble tatt i bruk på slutten av 1980- og begynnelsen av 1990-tallet har forbruket vært lavt.
Fra 1996 har forbruket ligget på mellom ½ og 1½ tonn aktiv legemiddelsubstans.
- Den samlede mengden antibakterielle midler på 212 kg (aktiv substans) benyttet til oppdrettsfisk i 2016, er det minste volumet rapportert siden midt på 1970-tallet, før fiskeoppdrett begynte å få et visst omfang, skriver de.
Flest til rensefisk
I følge data fra Veterinært legemiddelregister (Vetreg) er de aller fleste reseptene på antibiotika forskrevet til rensefisk, mens en svært liten andel av behandlingene av oppdrettsfisk er rettet mot laks i matfiskfasen.
- Imidlertid er biomassen til behandlet rensefisk liten sammenlignet med laks, og derfor bidrar mengden antibiotika til denne kategorien fisk relativt lite til det totale forbruket, understrekes det.
Ingen spesifikk sykdom dominerer
Oppgitte diagnoser som årsak til behandling av rensefisk er først og fremst sykdom forårsaket av «bakterieinfeksjoner generelt», og ikke spesifikke sykdommer.
- De vanligste bakterielle sykdomsårsakene diagnostisert ved Veterinærinstituttet hos rensefisk er atypiske Aeromonas salmonicida, ulike Vibrio-arter som V. anguillarum og V. ordalii. Pasteurella sp. og Tenacibaculim spp. er også påvist hos rognkjeks og ulike leppefiskarter, bl.a. i forbindelse med finneråte hos berggylt.